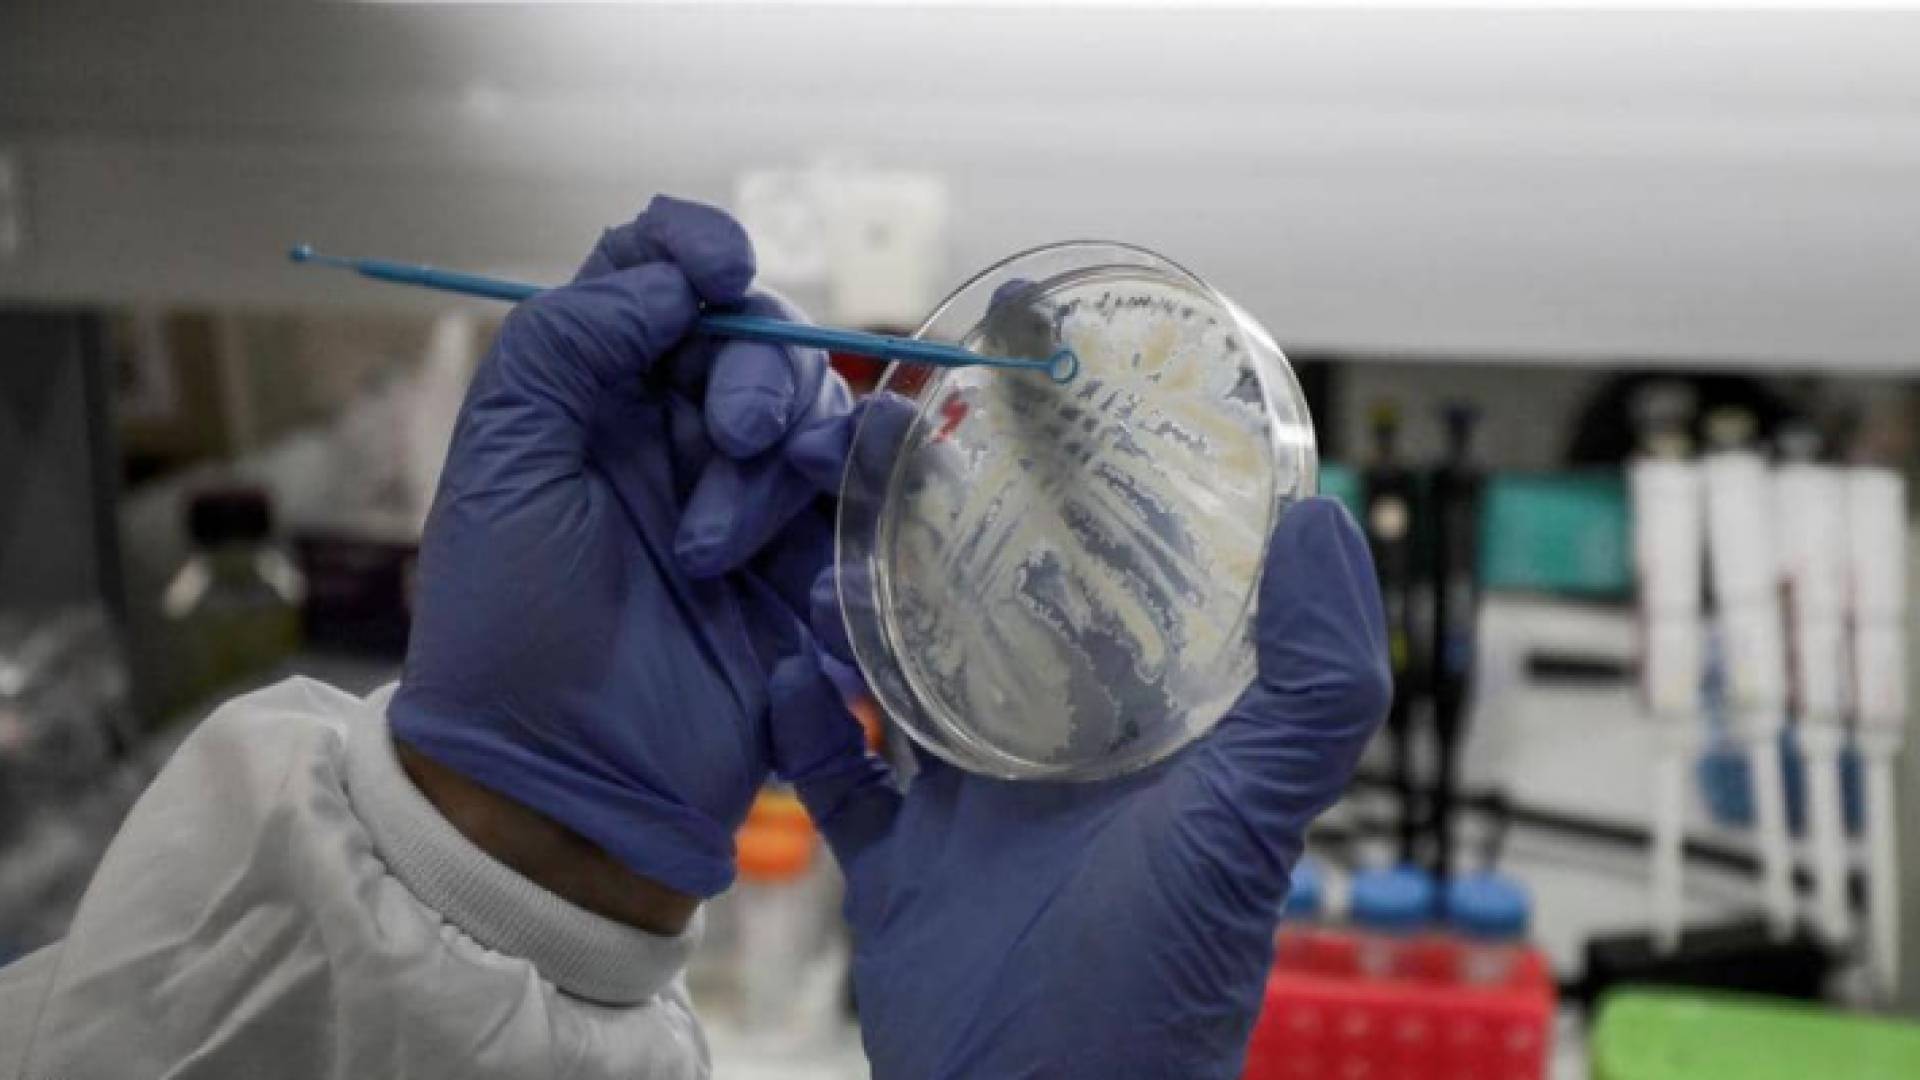
عدة تجارب تقوم بإجراء اللقاح ضد فيروس كورونا

عدة تجارب تقوم بإجراء اللقاح ضد فيروس كورونا
كيان الاحتلال يبدأ الاختبارات السريرية للقاح كورونا
يبدأ كيان الاحتلال الأحد القادم، الأول من تشرين ثاني، مرحلة الاختبارات السريرية للقاحها التجريبي المضاد لكوفيد-19، وفق ما أعلنت سلطات البلاد الساعية لكبح موجة تفش ثانية للوباء.
ومع بداية الجائحة أعلن رئيس وزراء الاحتلال بنيامين نتانياهو أنه فوض معهد الأبحاث البيولوجية "اي اي بي ار" الرسمي تطوير لقاح محلي مضاد للفيروس الذي أسفر إلى حد الآن عن وفاة أكثر من مليون شخص حول العالم بينهم 2372 في إسرائيل التي سجلت أكثر من 300 ألف إصابة.
والأحد، أعلنت سلطات الاحتلال أن الاختبارات السريرية الأولية للقاح التجريبي "بريلايف" ستبدأ في الأول من نوفمبر.
وهناك حاليا حول العالم نحو أربعين "لقاحا تجريبيا" في مرحلة الاختبارات السريرية (مقارنة بـ11 لقاحا في منتصف يونيو)، ونحو عشرة في المرحلة التقييمية الأخيرة التي تقاس فيها فاعلية اللقاح على عشرات آلاف المتطوعين الموزعين على مختلف القارات.
وتعتمد مقاربات مختلفة في موضوع اللقاحات، تتراوح بين تقنيات تقليدية وأخرى أكثر تقدما تقوم على استخدام نسخة محولة من فيروس آخر لمقاومة مرض كوفيد-19.
وتعتمد مختبرات معهد الاحتلال المقاربة الثانية، وقد أنتج لقاحها التجريبي "استجابة مناعية فاعلة" لدى حيوانات صغيرة مثل الفئران والأرانب، وأخرى أكبر مثل الخنازير، وفق مدير المعهد الطبيب شموئيل شبيرا.
وأكد شبيرا أن المعهد سيبدأ في الأول من نوفمبر المرحلة الأولى من الاختبارات السريرية على متطوعين يبلغان 18 عاما و55 عاما اختارهما مستشفيا "شيبا" و"هداسا".
وفي حال كانت النتائج الأولية إيجابية، ستنتقل السلطات إلى مرحلة ثانية من الاختبارات السريرية تشمل 80 متطوعا وبعدها مرحلة ثالثة وأخيرة تشمل 25 ألفا يتوقع ان تبدأ في أبريل أو مايو.
وإلى حد الآن تم إنتاج 25 ألف جرعة من اللقاح التجريبي، إلا أن المشروع يلحظ زيادة الإنتاج إلى 15 مليون جرعة، علما أن تعداد سكان كيان الاحتلال يقدر بنحو تسعة ملايين نسمة.